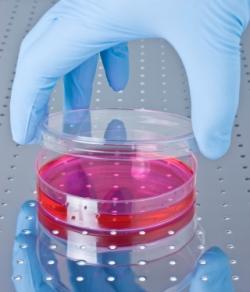
cellules souches

Agrandir l'image
Agrandir l'image
Paru le 2009-04-17 12:22:00
Angleterre - Une équipe de scientifiques de l’Institut de psychiatrie du King’s College de Londres a réussi à réparer le tissu nerveux du cerveau d’un rat, détruit à cause d’un AVC, grâce à une nouvelle technique utilisant des cellules souches neurales.
Cette technique utilise une matrice en polymère d’une taille infime. Plus d’un millier de ces matrices remplies de cellules souches neurales sont injectées dans l’espace laissé vide par l’AVC grâce à une très fine seringue peu invasive. Une IRM permet de localiser la zone à cibler et d’observer l’évolution du processus.
Les matrices viennent tapisser de façon exacte la cavité cérébrale vide. Les cellules souches peuvent alors former du tissu nerveux primitif en migrant le long des matrices. Ce tissu neuf permet d’établir de nouvelles connexions avec les neurones sains encore présents à la périphérie de la zone touchée. Ce processus se déroule en environ une semaine. Les matrices finissent par se dégrader, les espaces qu’elles libèrent étant alors à leur tour remplis par la croissance nerveuse et vasculaire du nouveau tissu.
Cette nouvelle étude offre de grands espoirs dans l’optique de traitement pour les humains. Les chercheurs se concentrent désormais sur l’ajout d’une protéine dans la matrice. La protéine VEGF favorise la croissance de nouveaux vaisseaux sanguins nécessaires à la croissance des cellules nerveuses du cerveau.


LES COMMENTAIRES (2)
posté le 25 mai à 01:08
ENFINNNN !!!! Nous avons besoin de vous ! Cette maladie est terrible, puissiez-vous changer nos vies des que possible ! Je dis "nous" mais ce serait plus exacte de dire "sa" vie, celle de ma mère tant aimée... Dieu vous guide et vous bénisse ! Qu'elle puisse à nouveau PARLER, simplement PARLER, qu'elle puisse à nouveau MARCHER... qu'elle puisse à nouveau revivre,..., que mon âme retrouve la paix, que moi et ma famille , et "sa" famille puissions REVIVRE, que NOUS puissions revivre. MERCI ! DEPECHEZ VOUS !!!
posté le 19 avril à 01:29
BJ VOUS ETES VRAIMENT DES GENS MAGNIFIQUES puisque VOUS VOULEZ DONNES L'ESPOIRE aux malades avec vos inventions bon courage que dieu vous dirige est vos protege pour lhumanite